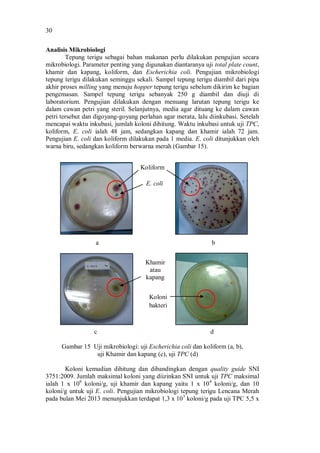

Gambar Aspirator 15liter Bahan Sains

Top 9 Most Popular Koyo Bamboo Foot Patch Brands And Get Free Shipping Lfd0bedb


Top 9 Most Popular Koyo Bamboo Foot Patch Brands And Get Free Shipping Lfd0bedb

Top 9 Most Popular Koyo Bamboo Foot Patch Brands And Get Free Shipping Lfd0bedb

Top 9 Most Popular Koyo Bamboo Foot Patch Brands And Get Free Shipping Lfd0bedb

Https Www Bukalapak Com P Perawatan Kecantikan Parfum Unisex 1s8a8oh Jual Diskon Promo Dupa Haji Rainbow Agarbatti Surratisurati Buhur India Stik Lidi 2019 06 17 0 5 Https Www Bukalapak Com P Hobi Koleksi Video Game Console 1s8a8om Jual Sale

Top 9 Most Popular Koyo Bamboo Foot Patch Brands And Get Free Shipping Lfd0bedb

Top 9 Most Popular Koyo Bamboo Foot Patch Brands And Get Free Shipping Lfd0bedb

Belum ada Komentar untuk "Gambar Aspirator 15liter Bahan Sains"
Posting Komentar